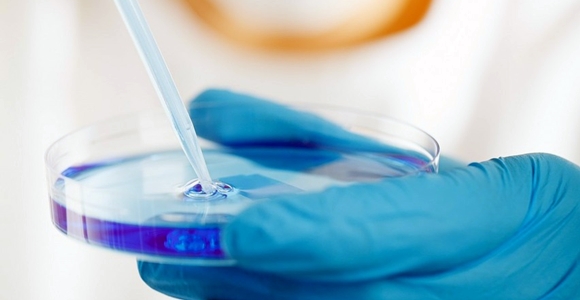

La mayoría ya nos hemos cansado un poco de una “payasada” que da vueltas en las redes sociales llamada “desafío del balde de agua fría”.
Parece poco probable que de esa campaña salga algo realmente prometedor para los enfermos de este mal. Sin embargo en Israel el panorama es mas alentador y hoy les contamos porque.
El Ice Bucket Challenge o también llamado desafío del balde de agua fría, es una campaña publicitaria solidaria que busca generar un “tipo de conciencia” poniéndose en el lugar de las personas que padecen una enfermedad muy extraña llamada Esclerosis Lateral Amiotrófica (ELA, o ALS por sus siglas en inglés), enfermedad degenerativa progresiva que ataca las neuronas motoras, haciendo que el cuerpo se sienta como si le tiraran una cubeta de agua fría, ya que el organismo baja mucho su temperatura.
Hablabamos de “payasada” cuando nos topamos con un video publicado por la compañía surcoreana Samsung, el modelo Galaxy S5, se somete al desafío Ice Bucket Challenge y además convocó a sus smartphones competidores (el iPhone 5S de Apple y el Nokia Lumia 930) a que puedan hacer lo mismo.
Entre las personalidades relevantes que padecen esta enfermedad se encuentra por ejemplo el físico Stephen Hawking.
Es curioso a la luz de esta nota que haya sido el propio Hawking quien se haya sumado hace algún tiempo a los boicots en contra de Israel.
Más interesante seria conocer los comentarios del propio Hawking al leer esta nota.
El desafío de la cubeta, también llamado así, consiste en arrojarse una cubeta de agua fría, que da la opción de desafiar a otras tres personas para que lo cumplan en las próximas 24 horas o deberán donar 100 dólares.
El dinero se recauda a beneficio como donación para la Asociación de Esclerosis Lateral Amiotrófica que estudia la enfermedad.
La ALS Association es una organización sin fines de lucro que tiene como principal fin la protección y cuidado y sobretodo asistencia a las personas que padecen esta enfermedad, a través de una interconectada red que tiene como sede principal Estados Unidos, además de un programa de investigación que está por todo el mundo con la labor de descubrir tratamientos y una posible cura para la enfermedad.
Personalidades que se han sumado al desafío para apoyar la causa cuentan a Alicia Machado, George W. Bush, Lionel Messi, Bill Gates, Taylor Swift, Neymar, Javier Hernandez Balcazar, Cristiano Ronaldo, Miguel Herrera, Migbelis Castellanos, Patricia Zavala, Lady Gaga, Shakira,Juanes, Demi Lovato, y Ashley Benson son algunos de los que han “aceptado el reto”.
;
Pero mientras todos estos “famosos” se divierten, un grupo de científicos israelíes (de quienes hemos contado hace ya algún tiempo) ha conseguido frenar por primera vez, el proceso degenerativo que produce la esclerosis lateral amiotrófica (ELA) con una nueva técnica de reinyección de células madre del propio paciente.
Ahora una nota en el conficencial.com da cuenta que la investigación, realizada en los últimos años en el hospital universitario Hadasa Ein Karem de Jerusalem, ha conseguido frenar por completo el avance de la enfermedad en algunos pacientes y en otros ha logrado incluso que se produzca una ligera mejoría en los músculos degenerados.
“El problema con la ELA y enfermedades similares es que un grupo de células nerviosas se degenera hasta morir de forma irremediable”, explicó el profesor Eldad Melamed, científico de la Universidad de Tel Aviv que participa en el proyecto, alentado por la empresa privada israelí Brainstorm.
La esclerosis lateral amiotrófica, se origina cuando las motoneuronas dejan de funcionar y van causando una parálisis muscular que acaba en la muerte a los pocos años.
Melamed explicó que la investigación ha sido muy difícil debido a que se desconocen las causas por las que estas neuronas dejan de funcionar y comienzan el proceso degenerativo, por lo que decidieron trabajar sobre las células madre del propio paciente.
“Las extraemos de la médula ósea, las limpiamos y las reproducimos en grandes cantidades. Después las tratamos con un proceso químico que las convierten en neuronas y las inyectamos en la espina dorsal y en los músculos afectados”, explicó sobre la técnica que ha desarrollado su empresa.
Los resultados que aseguran haber conseguido oscilan entre haber frenado la enfermedad en algunos pacientes y haberla detenido por completo en otros.
El informe afirma que la nueva técnica abre una ventana al optimismo para miles de pacientes, pero que está aún en fases preliminares de investigación y debe completar ensayos clínicos en Israel y en Estados Unidos.
Te gusta latamisrael.com?
Si respondiste “si” Sumanos tambien en Twitter.
Descubre más desde LatamIsrael
Suscríbete y recibe las últimas entradas en tu correo electrónico.

Hola,
muchas gracias por este interesante artículo. Una pregunta: el descenso de temperatura corporal es una consecuencia de la inactividad prolongada del cuerpo por su incapacidad de moverse, o un efecto específico de la enfermedad en si?
cordiales saludos
Ezequiel
esto si hay que difundirlo y no el baño con el baldazo que lo que logra es ridiculizar a la gente que si sufre esta enfermedad
Creo que el Sr Hawkins en su desesperación, espera más de sus compatriotas que de Israel y como todo ser humano falible, no comprendió el ridículo de la campaña iniciada para recaudar fondos.
Excelente nota. Se abre una esperanza para estos pacientes. Israel a la vanguardia en Salud.-
Dios ah bedecido a ISRAEL, ISRAEL ES SOBERANO GRACIA A DIOS POR ISRAEL.
COMO PUEDO COSEGUIR LA REVISTA OLITERATURA?
Es triste que para contar del avance israelí sobre el ALS tengáis que desmerecer la iniciativa de recaudar fondos para su investigación. A día de hoy, gracias a esta «payasada» se han recaudado casi 80 millones de dolares, y no solo eso, sino que se hizo visible una enfermedad casi desconocida para el gran público. Lástima que os canse una iniciativa solidaria como esta.
Gracias por tus comentarios Esteban.
Solo para aclarar nuestra opinión, no desmerecemos (sino al contrario) que se recauden fondos para investigar. Pero estamos convencidos que esos 80 millones (que no es una cifra tan grande al final de cuentas) son recaudables de formas mas creativas, menos ridículas y sobre todo utilizando recursos originales que muestren mas inteligencia que personas adultas haciendo «payasadas». Quizás haya una palabra mas adecuada pero no se nos ocurrió.
Es difícil ir contra la corriente, pero vamos escuchando muchas voces en contra de estas conductas ridículas que al ver que no son los únicos perplejos ante tanta » … » dejan escuchar su voz.
Por otro lado, si personas como las que mostramos con la influencia que tienen, quisieran realmente juntar dinero o informar sobre este terrible mal, lograrían un efecto mucho mayor, tanto económico como de información.
Por ultimo, no creo que ni el 10% de quienes ven personas tirarse baldes de agua fría en la cabeza, tengan o adquieran una remota idea de lo que esta terrible enfermedad significa. Cosa que sucedería si leyeran por ejemplo el primer articulo que publicamos.
Debería ser por ende un tanto preocupante ver un mundo donde la gente prefiere ver un video de un amigo (o desconocido) tirándose agua fría, que «leer» informacion sobre la enfermedad.
Agradecemos y respetamos tu opinión estimado Esteban, pero en esta ocasión se nos hace difícil de compartir.
Totalmente de acuerdo señor editor, hay tantas formas de comunicar y dejarse escuchar; Pero como es ISRAEL….siempre se le trata de minimizar las cosas importantes que aporta a la sociedad mundial, y resaltan hasta el cansancio que es un abusivo, cuando defiende a sus compatriotas de ataques terroristas. gracias.
Nada nuevo este artículo, ya que esta noticia se publico en agosto del año pasado y hasta ahora no hay mayor avance y quienes padecemos ELA, seguimos esperando que por fin salga a la luz la real cura.
A mi forma de pensar, todos estos avances ya han finalizado y la cura existe, pero las farmacéuticas solo están esperando crear una droga que nos mantenga.
Lamentablemente para estas empresas, somos poco rentables por ser muy pocos quienes la padecemos, es por eso que invertir en sanarnos a todos no es negocio y lo que buscan es crear algo que debamos consumir por años pagando altos costos.
Estoy de acuerdo con el Comenterio del Sr. Emilio. Mi esposo sufre de esta terrible enfermedad ELA hace 13 años. Somos minorias y no estan interesados en salvar vida. Los interesados son las Farmaceuticas, es triste decir esto pero es realidad. Muchos viven 3 a 5 años y un 10% mas 10 años. Actualmente mi esposo esta conmigo tiene un ventilador puesto y una computadora que le permite comunicarse con nosotros y esta programado con los ojos, postrado en una cama 24 horas, tiene poca movilidad en sus manos y piernas esta complementa paralizado. Es admirable la fe y esperanza que tiene, es duro tanto el enfermo como para la familia dia a dia esperando la cura.
Tenemos que buscar la manera de empujar y hacer conciencia a la sociedad y al mundo entero que ya es tiempo que nos oigan, tanto dinero para esutdios y investigaciones siguen buscando la cura, cuantos años mas tenemos que esperar, cuantas vidas vamos a perder, no es posible sigamos en la oscuridad.
Muchas Gracias
Melba
tengo un amigo cercano que hace algunos meses le diagnosticaron ELA, es muy agresiva en poco tiempo su habla se a dificultado mucho, su edad es de 67 años, me gustaría saber si hay posibilidades de contactarse con este centro de salud en israel, para enterarme si puede tenr alguna posibilidad de ser tratado por ellos.
saludos y quedo a la espera.
Estos son los enlaces que encontramos al respecto,
http://clinicaltrials.gov/ct2/show/study/NCT02017912?term=nurown+stemcell&rank=1
http://www.brainstorm-cell.com/index.php/clinical-trials/us-clinical-trials
Hola!…mi papa tiene esta enfermedad (ELA) aproximadamente desde hace 5 años, le ha avanzado muy lento gracias a dios, y creo que sus probabilidades de recuperación serian muy altas pues es un hombre muy fuerte, me gustaría que me orientaran para poder hacer contacto con el lugar donde hacen este procedimiento, para poder solicitar información. Les agradezco la ayuda!
Mira estos dos enlaces quizas alli les puedan ayudar:
http://www.brainstorm-cell.com/index.php/clinical-trials/us-clinical-trials
http://clinicaltrials.gov/ct2/show/study/NCT02017912?term=nurown+stemcell&rank=1
Yo creo que a pesar de ser ridiculo este acto ayuda a conseguir dinero para la investigacion,ya que no se pudo lograr de otra forma.cualquier sea la forma de conseguir debe ser alabada.
HOLA BUENAS NOCHES ESTOY INTERESADOEN ESTE TEMA YA QUE MI SUEGRO PADECE ESTA ENFERMEDAD TIENE APROXIMADAMENTE SEIS AÑOS Y PAULATINAMENTE SU DEGENERACION CONSISTE EN QUE EN SUS BRAZOS Y PIERNAS PIERDE FUERZA Y MOVILIDAD HOY EN DIA LE CUESTA TRABAJO RESPIRAR ESTAMOS PREOCUPADOS POR SU SALUD NO OBSTANTE DE LO MENCIONADO HACE MUCHO EJERCICIO EN SU BICICLETA ESTATICA TU ME PODRIAS RECOMENDAR ALGUN ESPECIALISTA EN MEXICO YA QUE HEMOS VISITADO MUCHOS MEDICOS Y MEDICINA ALTERNATIVA PERO TODOS HAN SIDO UN FRACASO TE LO VOY AGRADECER TU SERVIDOR CARLOS ASCENCIO mi correo es [email protected] gracias por tu atención.
Hola, no somos nosotros, nosotros solo difundimos informacion, la empresa segun entendemos esta aun realizando ensayos clínicos.
Tengo un hermano con ELA que puedo hacer para que sea tratado por ustedes?
Nosotros somos simplemente un medio de difusión, no una empresa medica. Estos son los datos de contacto de BrainStorm Cell Therapeutics.
BrainStorm Cell Therapeutics Inc.
Three University Plaza Drive
Suite 320
Hackensack, NJ 07601
Phone: 201-488-0460
Fax: 201-430-7555
E-mail: [email protected]
BrainStorm Cell Therapeutics Ltd.
12 Bazel St., POB 10019 Kiryat Aryeh,
Petach Tikva, Israel 49001
Tel: (972) 3.923.6384
Fax: (972) 3.923.6385
E-mail: [email protected]
Soy Antonio Gómez de la Cidad de México y tengo ELA, saben si en México se esta aplicando esta Técnica ?. Me agradaría inmensamente poder aplicarmela. Gracias!!!!!!
Probablemente en los Estados Unidos esten haciendo pruebas, quizas puedan informarle mejor en la embajada de Israel de su pais.
hola es lamentavle que a esta terrivle enfermedad. le den tan poca importancia mi hermano asus 41 años fue diagnosticado en marzo 2014 su enfermedad a avansado rapida mente el ahora esta conectado a un ventilador desgrasiada mente la mayoria de personas mueren por paros respiratorios oh ataques cardiacos mi ermano a. tenido 2paros respiratorias y un ataque cardiaco. el ahora esta en un hospital. de recuperacion lamentable mente. los doctores que lo.miravan lo dieron de alta con estas palabras. QUE ESPERE LA.MUERTE POR QUE SOLO LE QUEDAN 6 MESES DE VIDA.
vivimos en Usa segun el pais de las oportunidades. sin documentos sin ninguna esperansa por que no.lo podemos regresar a mexico y asta ahora los doctores que se cren dioses les quitaron el medicamento para esta.enfermedad segun ellos x que el.medicamento no esta asiendo su funcion lla que el no tiene lla ninguna movilidad es duro verlo asi lla que el era un ombre de dios dedicado a ayudar a su familia. Estraño tanto a mi ermano y pido conciensia clamo por ayuda por que en usa avemos personas con la.misma cituacion sin documentos hi sin ayuda económica.
tengo a mi hija de 15 anos que tiene esta enfermedad i quisiera comentarios de personas que se sometieron al tratamiento de celulas madres en israel
mi mama esta padeciendo de esa enfermedad por favor si alguien sabe mas informacion porlos q se sometieron al tratamiento de celulas madres en israel.
Necesito la cura urge muy avansado
MENDOZA MI HERMANA TIENE ESTA TRISTE ENFERMEDAD …..POR FAVOR UNA ESPERANZA
estos son los datos de contacto de la empresa:
BrainStorm Cell Therapeutics Inc.
Three University Plaza Drive
Suite 320
Hackensack, NJ 07601
Phone: 201-488-0460
Fax: 201-430-7555
E-mail: [email protected]
BrainStorm Cell Therapeutics Ltd.
12 Bazel St., POB 10019 Kiryat Aryeh,
Petach Tikva, Israel 49001
Tel: (972) 3.923.6384
Fax: (972) 3.923.6385
E-mail: [email protected]
A mi lo que me asombra, es que George W. Bush, tenga la caradurez de realizar este desafio para recaudar fondos para instituciones que investiguen tratamiento y cura de esta horrible enfermedad, y mostrarle a la audiencia que se preocupa por esas enfermedades, cuando todos sabemos que tanto él como el partido republicano al cual pertenecen sus ideales, estan en contra de buscar curas con celulas madres, o como las llaman ellos «Stem Cells», acusando (junto con la iglesia) que el hombre no puede jugar a ser dios.
Claro, el hombre no puede jugar a ser Dios, porque no existe tal. El hombre evoluciona, porque tiene razociño, tiene un cerebro en constante evolución y todo sigue su curso hacia adelante, tanto el hombre, como la explosion del Big Bang que todavia continua y sigue expandiendo estrellas, soles y galaxias por todo el espacio.
Me encantaria saber a todas esas personas conservadoras que no quieren que el hombre avance, y encuentre curas para enfermedades terribles, y tratamientos avanzado para mejorar la calidad de vida de los desafortunados con enfermedades neurologicas, cardiacas, geneticas, musculares y demás… qué pasaria si les ocurriera una enfermedad como la ELA, o el Parkinson, a ellos… o peor aun a sus hijos, y tengan que verlos sufrir por años?… SEGUIRIAN OPINANDO LO MISMO?
Dios quiera que exista la posibilidad de la cura para ELA, es urgente y necesaria, yo estoy afectada y es muy lamentable porque tengo una hija de tan sólo 5 años, quiero y deseo con ansias volver a tomar la mano de mi hija y caminar junto a ella, no quiero que se me vaya la vida, quiero una oportunidad, porfavor dios bendice e ilumina a los científicos para que nos devuelvan las ganas de seguir luchando
Alma Danae Peralta Martinez
Número de cuenta para difundir y sigan con el propósito, porfavor esnecesaria la cura y la vida
Alma Peralta
Hola soy jaime tengo ela y tengo mucha pena por q tengo tres hijos ee 12 ,5 y 4 años y me cuesta saber q tengo q separarme de ellos y de mi amada esposa me encomiendo a dios todos los dias para q me de fuerza y poder soportar esto ojala q la cura este a un alcanse axecible y q sea pronto para todos los q padecemos de esta enfermedad
necesito el correo para comunicarme con el lugar donde se realiza esta cura por favor gracias
buscar el Hospital Hadasa en Jerusalem
BrainStorm Cell Therapeutics Inc.
Three University Plaza Drive
Suite 320
Hackensack, NJ 07601
Phone: 201-488-0460
Fax: 201-430-7555
E-mail: [email protected]
BrainStorm Cell Therapeutics Ltd.
12 Bazel St., POB 10019 Kiryat Aryeh,
Petach Tikva, Israel 4900101
Tel: (972) 3.923.6384
Fax: (972) 3.923.6385
E-mail: [email protected]